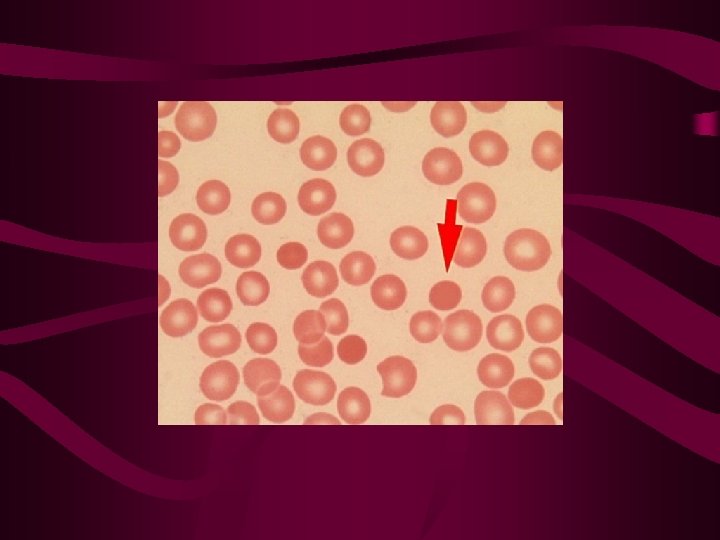
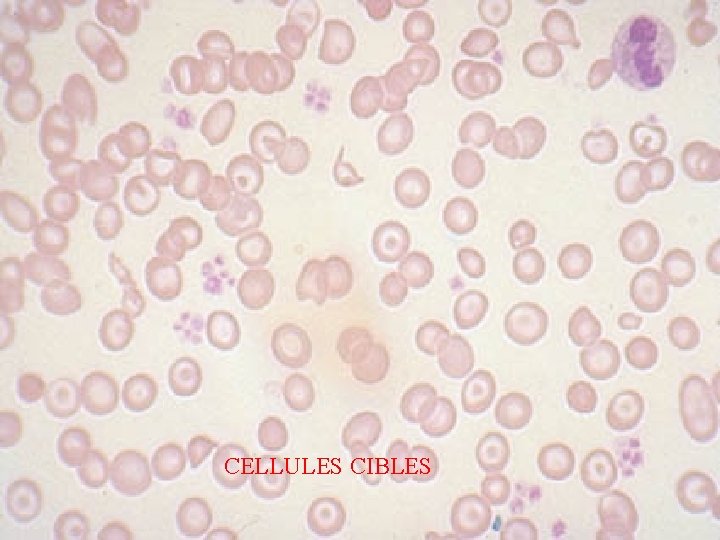
CELLULES CIBLES
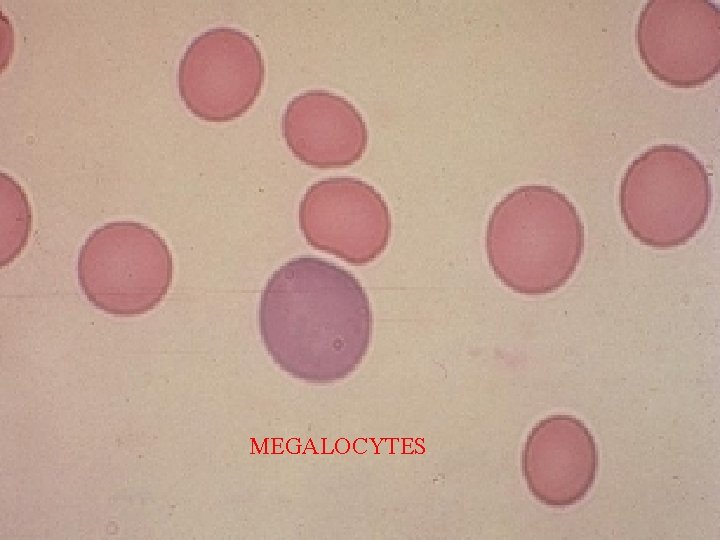
MEGALOCYTES
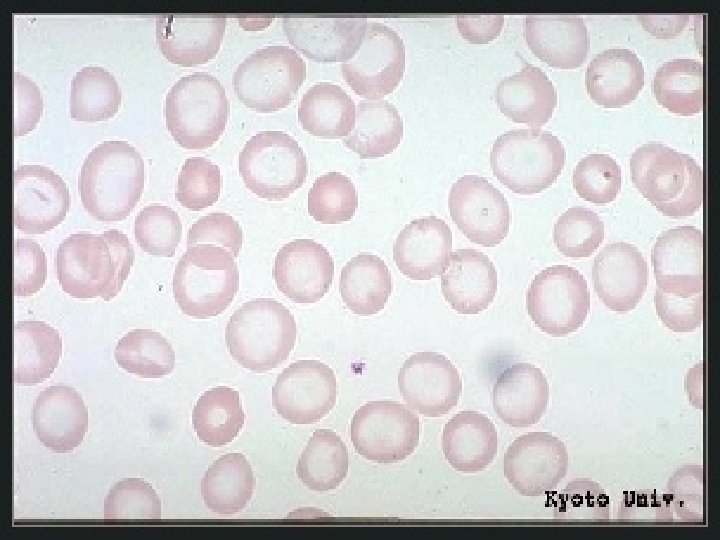
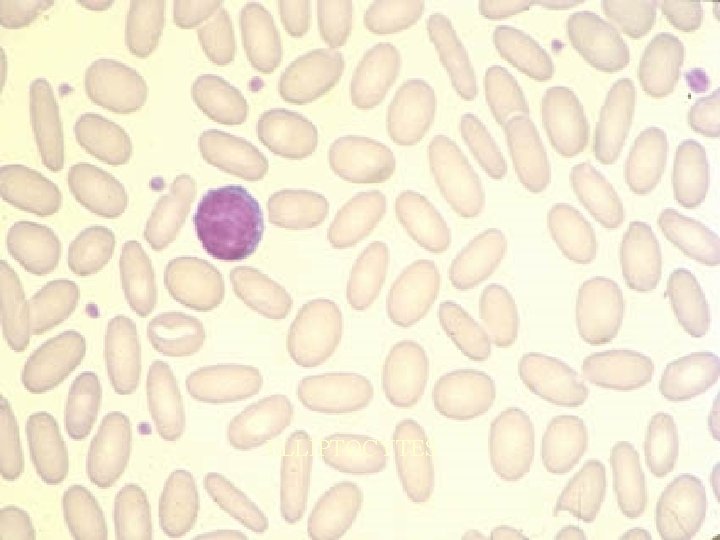
ELLIPTOCYTES
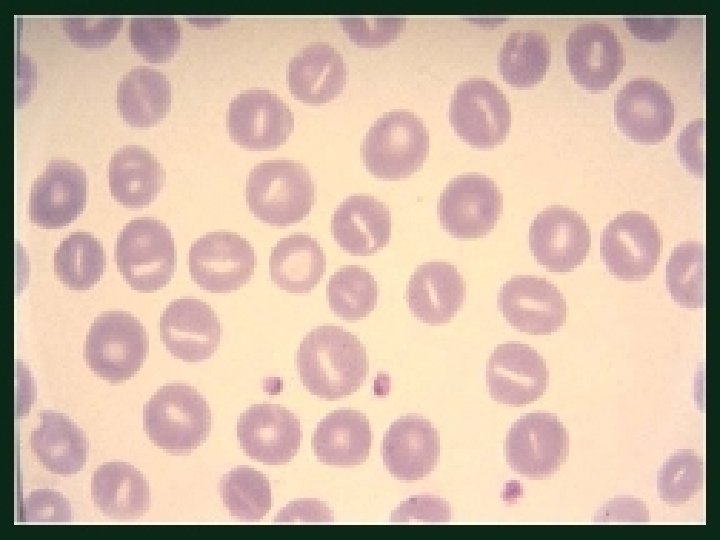
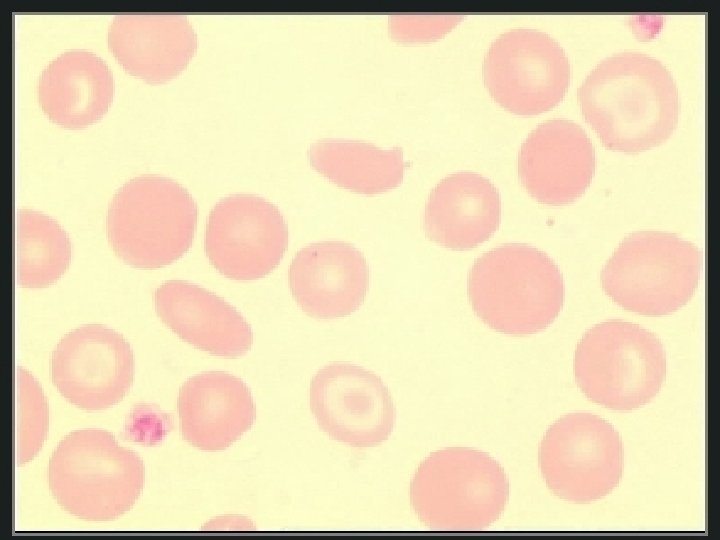
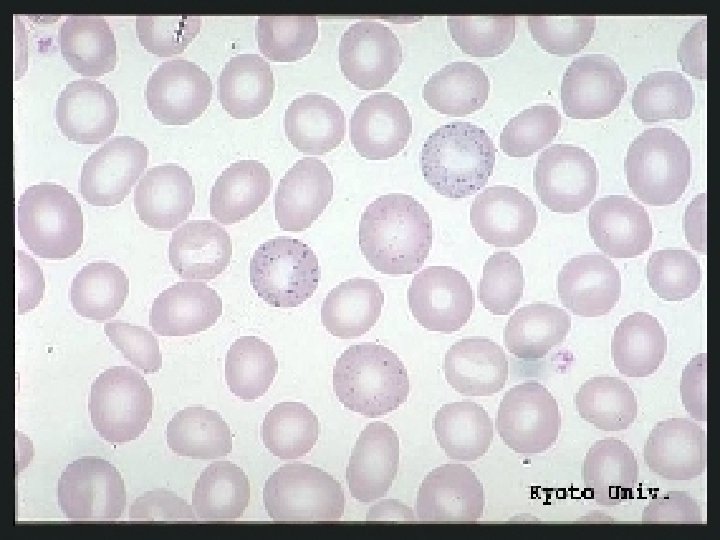
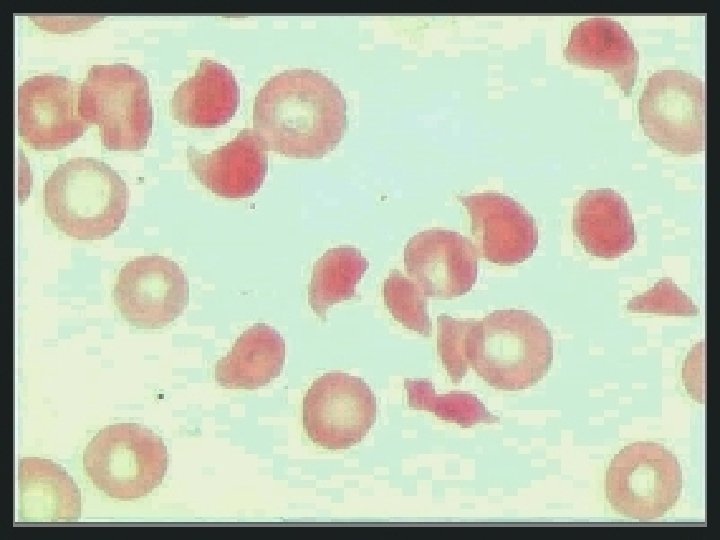
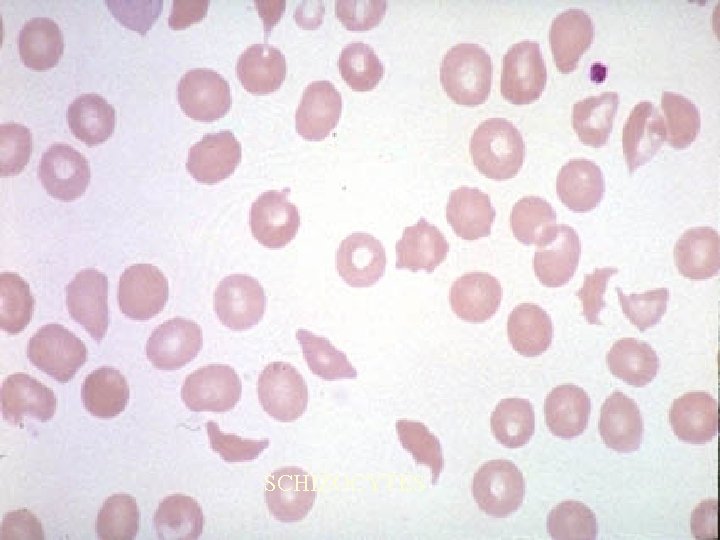
SCHIZOCYTES
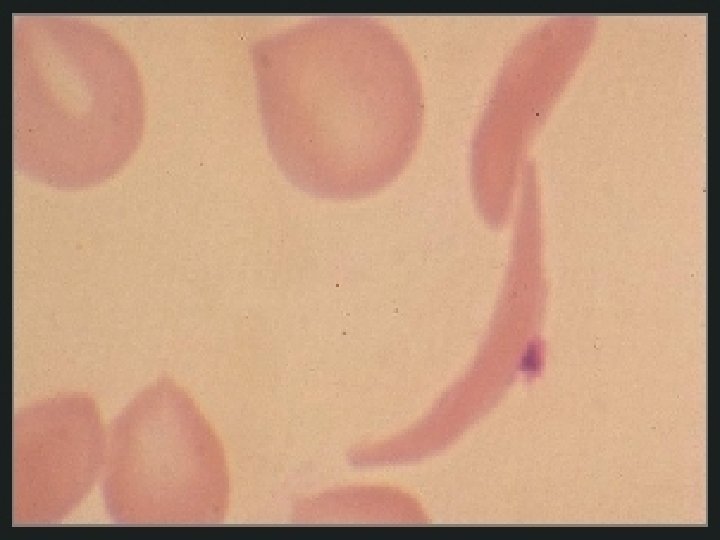
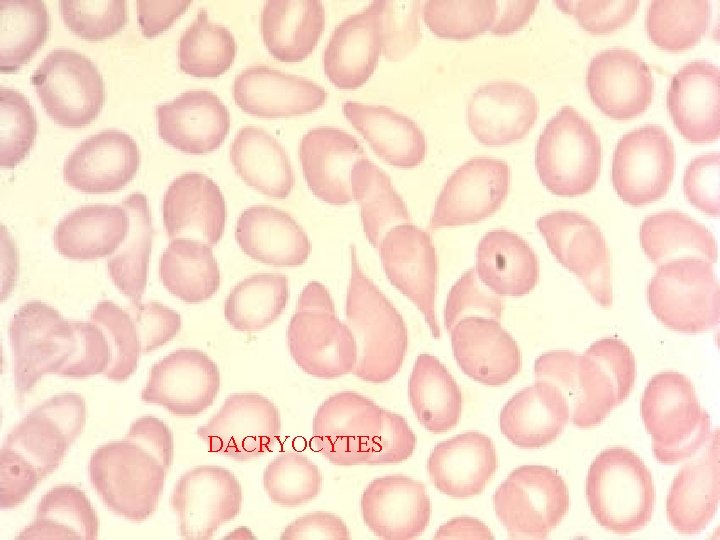
DACRYOCYTES
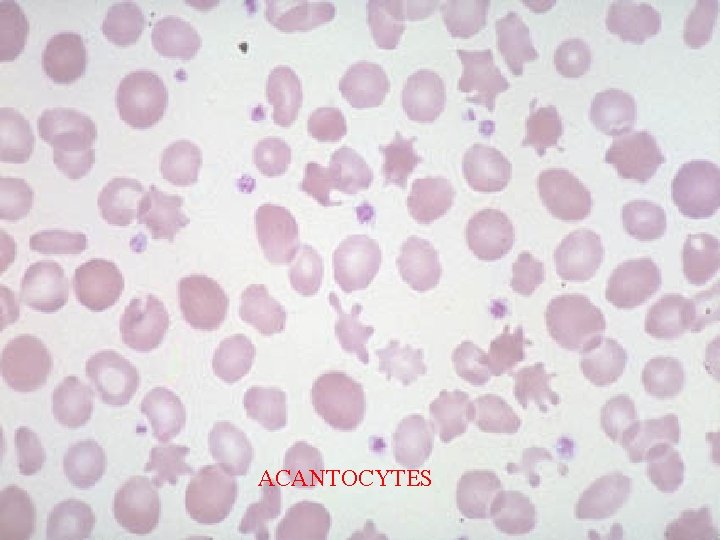
ACANTOCYTES

LES ANEMIES Dfinir les anmies Connatre les lments

- Slides: 100
LES ANEMIES
- Définir les anémies - Connaître les éléments cliniques de l’anémie. - Différentier les états d’anémies d’autres syndromes - Savoir calculer les indices hématimétriques - Donner l’intérêt du frottis sanguin. - Réaliser une classification morphologique de l’anémie - Connaître les signes cliniques particuliers aux carences : (en fer, en vit B 12, en folates). - Connaître les signes cliniques particuliers des hémolyses. - Citer les cas où une transfusion sanguine est nécessaire. - Décrire la technique de réalisation des différents tests diagnostics et interpréter les résultats obtenus. -Citer les traitements des différentes anémies.
DEFINITION l. Définition anémie : - le taux d'hémoglobine - et non par le chiffre des GR l La quantité d'O 2 transportée ne dépend : - ni du nombre de GR/ml - ni du volume qu'ils occupent par rapport au plasma ( Hématocrite) èmais de la quantité d'hémoglobine/ml
On parle d’anémie si taux d’hémoglobine : - < 13 g/100 ml chez l’homme - < 12 g/100 ml chez la femme et l’enfant - < 11 g/100 ml chez la femme enceinte et le vieillard o Interprétation des résultats en l’absence - d’hémodilution : • d’hypergammaglobulinémie • d’insuffisance cardiaque • de cirrhose du foie ou insuffisance rénale • d’hypersplénisme - ou d'hémoconcentration (diurétiques, déshydratation)
RAPPEL l GR = sac rempli exclusivement d'hémoglobine (33%). autres constituants du GR = fonction de protéger l'Hb de l'oxydation pour assurer son fonctionnement optimal. l Fonction essentielle de l'Hb: transport O 2. lors de la baisse de la Pa. O 2 tissulaire Production d‘EPO par le cortex rénal EPO augmente la synthèse d'érythroblastes dans la MO- réticulocytose dans le sang
• GR produits dans MO à partir des érythroblastes. Au stade ultime de maturation, les érythroblastes perdent leur noyau et passent dans le sang sous forme de réticulocytes. • Les réticulocytes achèvent leur maturation en 24 h, deviennent GR qui circuleront 120 j avant d’être détruits dans les macrophages de la moelle. • V. N. = 0. 5 -1. 5 %
DIAGNOSTIC BIOLOGIQUE Ø Hémoglobine ØFerritine ØVGM ØMyélogramme ØCCMH ØBilirubine ØTCMH ØHaptoglobine ØRéticulocytes ØLDH ØFer sérique ØAnticorps
L’érythropoïèse est la coordination de 2 processus : 1. synthèse de l’hémoglobine dans le cytoplasme avec des besoins particuliers en fer; 2. une multiplication qui nécessite une intense synthèse d’ADN et donc un besoin en acide folique et en vitamine B 12.
Régulation de l’érythropoïèse: Erythropoïétine: glycoprotéine synthétisée par les cellules juxtaglomérulaires du rein. Stimuli: Hypoxie Action: différenciation des cellules souches érythropoïétiques.
PRINCIPAUX MECANISMES DE L'ANEMIE A - Les anémies périphériques : t Par destructions ou pertes +++ production d‘EPO taux de réticulocytes. t Il peut s'agir : - Destruction intra-vasculaire : Dans l'espace de distribution normal des GR. - hyperhémolyse - extracorpusculaire : attaque du Gr/agent extérieur - intracorpusculaires = maladies du GR - Disparition par sortie des GR de l'espace vasculaire : Hémorragie
B - Les anémies centrales : Par défaut de production. La moelle n'assure plus sa fonction érythropoïetique réticulocytose basse. u défaut de production de EPO : IR u défaut de la sensibilité des érythroblastes à EPO : érythroblastopénie constitutionnelle de Blakfan-Diamond. u inhibition immuno de l'érythropoïèse : Ac antiérythroblastes des thymomes u envahissement médullaire qui diminue l'espace fonctionnel des érythroblastes: F F par des cellules hématopoïétiques : par des cellules non hématopoïétiques : métastases leucémies
u Diminution de la synthèse de DNA des érythroblastes : u carence B 12/folates = anémies mégaloblastiques u défaut de synthèse de hémoglobine : Fanomalie du métabolisme du fer : Øcarence du fer (martiale), Øanomalie du stockage : anémies inflammatoires, Øanomalie de l'absorption du fer (atransferrinémie) F anomalie de la synthèse de globine : thalassémie F par anomalie de la synthèse de hème: porphyries
DIAGNOSTIC POSITIF DE L'ANEMIE A - CLINIQUE 1 - Signes fonctionnels : l Il peut s'agir : Fde signes cardiovasculaires : -dyspnée d'effort ou de repos -palpitations, lipothymies -douleurs /ischémie, notamment dans territoires où les artères sténosées : artérite, angor F de signes neurosensoriels : -acouphènes, scotomes - vertiges, céphalées
l Plus ou moins bruyant selon : Fla rapidité de l'installation F l'activité physique F l'état cardiovasculaire 2 - Signes généraux : Asthénie à l'effort puis au repos. 3 - Signes Physiques : a - Signe direct = Pâleur FÉvidente aux extrémités : ongles, lèvres, muqueuse buccale, conjonctives oculaires. F Masquée par : l'ictère, la cyanose, la pigmentation raciale. F Confondue avec le myxœdème, le vitiligo.
b - Signes indirects de l'anémie : F souffle systolique de pointe "anorganique" 4 - ECG : Modifications en cas d'anémie sévère, réversibles à la correction de l'anémie : usous décalage de ST uonde U uonde T aplatie Moins fréquents mais possibles : uallongement QT utroubles de la conduction auriculo-ventriculaire
B - DIAGNOSTIC POSITIF 1 - FORME TYPIQUE : hémolyse chronique a - Clinique : triade hémolytique b - Biologie : 1) Signe d'hémolyse : - anémie - augmentation des produits du catabolisme GR - bilirubine libre élevée - haptoglobine effondrée - augmentation du fer sérique - augmentation des LDH 2) Signe de régénération médullaire : - sang : réticulocytose > 120 000/mm 3 - MO : érythroblastose médullaire > 30 %
D - DIAGNOSTIC ETIOLOGIQUE 1 - SIGNES ORIENTATION a - Interrogatoire antécédents familiaux éthniques personnels : ictère dans l'enfance récents : prise thérapeutique syndrome infectieux b - Examen : anomalies évocatrice d’une étiologie: Fcheveux secs et ongles cassants ferriprive F ulcères de jambe anomalie de l'Hb F glossite F atteintes neurologiques carence en Vit B 12 F hypotrophie, retard staturo-pondéral F hippocratisme digital origine congénitale
CALCULS • VGM: Ht / GR par mm 3. • TCMH: Taux d'hb / GR. • CCMH: Taux d'hb (g/100 ml)/ Ht x 100.
2ÈME ÉTAPE : OBSERVER LA TCMH ou CCMH et LE VGM + La TCMH ou CCMH définit la normochromie Normes de TCMH (27 pg -32 pg) TCMH > 27 pg ou CCMH nle à anémie normochrome TCMH < 27 pg ou CCMH < 32% à anémie hypochrome (l'hyperchromie n'existe pas) + Le VGM définit la normocytose (80 ft) VGM < 80 m 3 à anémie microcytaire VGM > 100 m 3 à anémie macrocytaire
3ÈME ÉTAPE : TROIS SITUATIONS POSSIBLES + anémie avec TCMH et VGM diminués + anémie avec TCMH et VGM normaux + anémie avec VGM augmenté
2 - Etude du frottis: a - Carence martiale : hypochromie : GR décolorés (VGM diminués) anisocytose : anomalies de taille poïkilocytose : anomalie de forme b - Anomalies de la membrane érythrocytaire : microsphérocytose : maladie de Minkowski. Chauffard elliptocytose stomatocytose
c - Anomalies de l'Hémoglobine : hématies en cible : Thalassémie ou Hémoglobinose E hématies en faucille : drépanocytose d - Anomalies des Enzymes : hématies ponctuées, corps de Heinz = met. Hb résiduelle en présence d'un oxydant e - Anomalies acquises : schizocytes : hématies fragmentées (sd Moschowitz) dacryocytes : GR en forme de larme (myélofibrose) echinocytes : GR en forme d'oursin présence de parasites intra GR: Paludisme
3 - Étude des différents constituants des GR a - Étude de la membrane : étude de la résistance osmotique immédiate et après 24 h résistance globulaire aux solutés hypotoniques électrophorèse des protéines membranaires b - Étude de l'Hémoglobine : -4 chaînes de globine chromosome 16 les 4 gênes a chromosome 11 les gênes b, g, d - Hémoglobine chez l'adulte: Hb. A a 2 b 2 97 %, Hb. A 2 a 2 g 22%, Hb. F a 2 d 2 1 % exploration des anomalies de l'Hémoglobine - test de falciformation - électrophorèse de hémoglobine: Hb anle; % Hb. A 1, A 2, F - étude du 2 -3 DPG et de la courbe de dissociation de l'Hb - étude en biologie moléculaire des gênes de la globine
c - Test de Coombs: 1 Le test de coombs direct (TCD) détecte Ac situés à la surface des GR par un anticorps anti-Iglo. (anti-Ig. G, anti. Ig-A, anti-C'). dépiste une auto-immunisation antiérythrocytaire 2 - Le test de coombs indirect (TCI) détecte Ac sériques libres dans le sérum : a) fixation des AC libres sur des GR témoins b) test de Coombs direct dépiste des agglutinines irrégulières (alloimmunisation)
4 - Étude de la durée de vie des GR: 1 - Technique par marquage isotopique au Chrome 51 ou Indium. Demi-vie normale calculée par le temps de demidisparition de la RA initiale corrigée par l'élution spontanée du chrome. - 28 jours +/- 3 -< 28 jours : hémolyse excessive Lieu de séquestration étudié par comptage externe : -Splénique -mixte : hépatosplénique -au hazard
c - Radiographies : anomalies de la voûte du crâne épaississement des os de la voûte "en poils de brosse « brachycéphalie F visage mongoloïde lithiase pigmentaire anomalies morphologiques des mains doigts : poly, brachy, syndactylie
L'ANÉMIE EST MICROCYTAIRE
L'ANÉMIE EST HYPOCHROME ET MICROCYTAIRE (TCMH < 27 pg et VGM < 80 m 3) o Quelle qu'en soit la cause, le mécanisme qui explique l'anémie est central et correspond à un trouble de la synthèse de l'hémoglobine. o L'examen clé est le dosage du fer sérique couplé à celui de la capacité totale de fixation du fer par la sidérophiline (ou transferrine), dont le rapport donne le coefficient de saturation.
Dans la très grande majorité des cas, le fer sérique est diminué. Il s'agit alors soit d'une anémie par carence martiale, soit d'une anémie inflammatoire. Lorsque la capacité totale de fixation du fer par la sidérophiline est élevée, l'anémie est due à une carence en fer. Lorsque la capacité totale de fixation est abaissée, l'anémie est la conséquence d'un syndrome inflammatoire qui doit être suffisamment important et prolongé (plusieurs mois) pour séquestrer du fer et induire une microcytose.
Lorsque la capacité totale est normale, l'hypothèse d'une anémie mixte, provoquée à la fois par une carence martiale et un syndrome inflammatoire, doit être envisagée. Dans ce cas, l'analyse du contexte clinique associée aux chiffres de la VS et de la protéine C réactive doit permettre d'apprécier s'il y a discordance entre l'anémie et le syndrome inflammatoire. Dans le doute, on peut s'aider d'une ferritinémie. L'effondrement du taux sérique de cette protéine de réserve labile du fer signe de façon pathognomonique une carence martiale. Dans l'hypothèse rare d'un fer sérique nl ou élevé électrophorèse de l'hb qui permettra de séparer syndrome thalassémique et anémie sidéroblastique.
Anémies microcytaires : Le simple dosage du fer sérique est sans intérêt o La carence en fer affirmée, quelle en est l'origine ? La cause la plus fréquente est la perte de fer par des saignements peu importants, méconnus ou négligés, mais répétés pendant des mois : · saignements gynécologiques (règles abondantes, hémorragies fonctionnelles ou organiques) ou · digestifs (hernie hiatale, cancer gastrique, colique, hémorroïdes, Rendu-Osler).
En dehors des saignements, il faut penser · aux carences d'apport surtout chez l'enfant, la femme enceinte et la personne âgée dénutrie, et · aux carences d'absorption gastrectomie) plus rarement. (maladie cœliaque, o Le traitement martial doit non seulement réparer l'anémie mais aussi rétablir les réserves en fer de l'organisme. Il doit toujours comporter un apport de fer per os, fournissant 100 à 200 mg de fer métal jour. Au-delà de cette dose, il y a un risque de mauvaise tolérance sans amélioration de l'efficacité (saturation des capacités d'absorption). L'adjonction de vitamine C semble améliorer l'absorption.
Il est préférable que le traitement soit pris le matin à jeun, car les aliments diminuent l'absorption. En revanche, la tolérance gastro-intestinale n'est pas toujours bonne. Il faut prévenir que le patient va observer des selles noires. Le traitement sera poursuivi pendant au moins trois mois et ne sera interrompu qu'après vérification de la normalisation de l'hémoglobine, du VGM et du bilan du fer. La nécessité du traitement martial ne saurait occulter celle d'une enquête étiologique
ANÉMIES MICROCYTAIRES avec fer sérique bas : 2 étiologies : Carence martiale et Inflammation
CAUSES DE CARENCE EN FER. Besoins en fer augmentés - période de croissance rapide de l'enfance et de l'adolescence. Apports en fer diminués - régimes riches en céréales, pauvres en viandes - sous-alimentation (personnes âgées et indigentes). Diminution de l'absorption du fer - achlorhydrie - gastrectomie partielle ou totale - affections chroniques du grêle - malabsorption (maladie cœliaque, . . . )
. Pertes physiologiques de fer - menstruations, grossesse. Pertes de fer pathologiques - gynécologiques: fibrome ou polype utérin, cancer utérin, déséquilibres hormonaux, dispositif intrautérin - digestives • hernie hiatale, œsophagite peptique, varices œsophagiennes • gastrite, ulcère, cancer de l'estomac, aspirine et AINS, polype et cancer colo-rectal, maladie de Crohn et rectocolite hémorragique • angiodysplasies coliques, hémorroïdes
Traitement martial
ASCOFER® : (Ascorbate ferreux) gélules à 33 mg de fer métal. Adulte : 100 à 200 mg de fer métal par jour, soit 3 à 6 gélules par jour FERROSTRANE® : (Férédétate de sodium) sirop dosé à 34 mg de fer métal par c. à café : 100 à 200 mg de fer métal par jour, soit 3 à 6 c. à c. par jour. FEROGRAD vit C 500® : (sulfate ferreux) comprimés à 105 mg de fer métal. 100 à 200 mg de fer métal par jour soit 1 à 2 comprimés par jour TARDYFERON 80 mg® (sulfate ferreux) comprimés à 80 mg de fer métal Adulte : 1 à 2 comprimés par jour TARDYFERON B 9® (sulfate ferreux, ac. folique) comprimés à 50 mg de fer métal et 350 mg d'acide folique Traitement préventif des carences en fer et en acide folique au cours de la grossesse 1 comprimé/jour à partir de la 24ème semaine de grossesse
• CARENCE EN FER : Donner du fer, OUI, …mais cher aussi la cause!
L'ANÉMIE EST NORMOCHROME et NORMOCYTAIRE
L'ANÉMIE EST NORMOCHROME ET NORMOCYTAIRE (FS) • Premier examen Réticulocytaire. demandé: o > 120. 000/mm 3 ANN Régénérative. 2 grandes étiologies: • Hémorragies aiguës: diagnostic évident • Hémolyses. Numération
Selon l'anamnèse, l'âge, les antécédents, l'enquête familiale, on fait la part entre les hémolyses congénitales et les hémolyses acquises o Si réticulocytose normale ou basse trouble de la production. -- Éliminer: anémie début, insuffisance endocrinienne inflammatoire au rénale ou cause -- Reprendre l'hg: anémie isolée ou associée à une modification quantitative et/ou qualitative des leucocytes et des plaquettes.
Le myélogramme est nécessaire MO riche il peut s’agir d’une: • érythroblastopénie • dysmyélopoïèse acquise idiopathique (AREB ou ASAI) • dysmyélopoïèse acquise secondaire (chimio au long cours) • envahissement médullaire (métastases, leucémie, myélome, lymphome malin. . . ) MO pauvre PBO: aplasie médullaire ou envahissement de la moelle avec myélofibrose réactionnelle.
DIAGNOSTIC DES ANÉMIES HÉMOLYTIQUES 1 Anémies hémolytiques corpusculaires (congénitales) - Anomalies de la membrane globulaire ØSphérocytose héréditaire (Minkowsky-Chauffard ) - Anémie normocytaire normochrome très régénérative: Mesure de la fragilité osmotique des hématies, Test d'autohémolyse avec et sans glucose • . Anomalie sur le frottis : microsphérocytose abondante • Hyperbilirubinémie et hypohaptoglobinémie Ø Elliptocytose héréditaire: anomalie spectrine Ø Hémoglobinurie Paroxystique Nocturne (HPN): sensibilité anormale au complément (déficit en inhibiteur)
- Anomalies de l'hémoglobine Hémoglobinopathies : - drépanocytose - hémoglobine instable - trouble de l'affinité pour l'O 2 - Déficits enzymatiques: G 6 PD ou Pyruvate-kinase
A. 2 - Anomalies de l’Hémoglobine A. 2. 1 -Anomalies quantitatives constitutionnelles de la synthèse de globine • Syndromes Thalassémiques: diminution ou absence de synthèse d'une ou plusieurs chaînes de globine : a-Thalassémies et b-Thalassémies. • Les b-Thalassémies Populations : Bassin méditerranéen (Grèce, Italie du Sud, Sicile, Sardaigne, Afrique du Nord), Asie du Sud-Est, Moyen Orient, Afrique noire, Antilles, Noirs américains. Altérations génétiques : 150 mutations ponctuelles connues (délétions plus rares), affectant le promoteur des gènes b, les mécanismes d'excision-épissage, ou le signal de terminaison de traduction. b thalassémie majeure ou maladie de Cooley Anémie n'apparaissant pas à la naissance car synthèse Hb. F restant majoritaire, donc diagnostic établi entre 3 mois et 18 mois. Anémie sévère (Hb entre 4 et 7 g/dl), microcytaire et hypochrome, peu régénérative. Anomalies sur le frottis caractéristiques : microcytose, poïkylocytose, elliptocytes, hypochromie, annulocytes et hématies cibles, ponctuations basophiles, et érythroblastose sanguine (imposant la correction de la numération leucocytaire).
2 Anémies hémolytiques corpusculaires (acquises): Toxiques Bactériennes, virales, parasitaires Immunologiques: Anémie auto-immune A. Hémo. médicamenteuse Maladies des agglutinines froides Hémoglobinurie paroxystique nocturne ( Test de Coombs, Test de Coombs avec et sans médicament, Dosage et identification des agglutinines froides, Test de Ham Dacie (sensibilité au C' en milieu acide) Mécaniques: Prothèse valvulaire, CEC, CIVD, microangiopathie, métastases (Recherche de schizocytes)
RETENIR ANÉMIES RÉGÉNÉRATIVES • Deux grandes étiologies : Hémorragie aiguë Hémolyse
L'ANÉMIE EST MACROCYTAIRE
L'ANÉMIE EST MACROCYTAIRE (VGM > 100 fl) o Premier examen demandé: Réticulocytes. Possible hémolyses fortement régénératives, le réticulocyte ayant un VGM supérieur à celui du globule rouge mature. o Les anémies macrocytaires sont le plus souvent arégénératives par insuffisance de production médullaire: o Première démarche: penser à l'éthylisme chronique. C'est la cause la plus fréquente des macrocytoses modérées (100 à 110 m 3) en général sans anémie (mécanisme complexe, une carence en folates souvent associée).
En l'absence d‘éthylisme, une anémie macrocytaire isolée, sans atteinte des lignées leucocytaires ou plaquettaires, doit faire évoquer une insuffisance thyroïdienne qui sera confirmée par le bilan hormonal. o En dehors de l'éthylisme chronique, les anémies macrocytaires non régénératives sont dues le plus souvent à une carence en vitamine B 12 et/ou en folates, ou à un syndrome myélodysplasique surtout chez le sujet âgé. Demander un myélogramme et un dosage de la vitamine B 12 et des folates qui vont permettre de les différencier.
CAUSES DES CARENCES EN FOLATES. Carences d'apports malnutrition, régime déséquilibré, ébullition prolongée des aliments. Malabsorptions maladie cœliaque, sprue tropicale, résection jéjunale, affections du grêle (lymphomes, etc. ). Excès d'utilisation ou de pertes - Physiologiques: grossesse, allaitement, prématurité - Pathologiques affections hématologiques, anémies hémolytiques myélofibrose, cancers, lymphomes maladies inflammatoires dialyses
. Alcoolisme et hépatopathie. Carences aiguës en folates malades en réanimation, infections sévères chez les sujets carencés. Médicaments antifoliques : méthotrexate, pyriméthamine, triméthoprime sulfasalazine : malabsorption anticonvulsivants
CAUSES DES CARENCES EN VITAMINE B 12: . Carences d'apports végétariens stricts. Malabsorptions - Causes gastriques: maladie de Biermer gastrectomie partielle ou totale - Causes intestinales: maladie de Crohn, sprue tropicale, maladie cœliaque, pullulations microbiennes, résection iléale étendue, infestation par le botriocéphale. Causes médicamenteuses colchicine : malabsorption protoxyde d'azote : inactivation de la B 12
Schéma thérapeutique d'une carence en B 12 • B 12 Intramusculaire; très rarement orale • 100 µg tous les 2 j pendant 15 j à 1 mois • 100 µg/mois (à vie si gastrectomie ou malabsorption irréversible) Acide folique et Acide folinique Orale : acide folique 5 à 10 mg/jour Orale ou injectable : acide folinique variable selon l'indication Fonction de la cause : - limitée (quelques mois) en cas de grossesse ou de carence d'apports - longue durée si dialyse ou hémolyse congénitale
DIAPORAMA
GR NORMAUX
CORPS DE JOLLY
CELLULES CIBLES
HYPOCHROMIE
MACROCYTES
POLYCHROMATOPHILIE
POST SPLENECTOMIE
RETICULOCYTES
STOMATOCYTES
MEGALOCYTES
ELLIPTOCYTES
SCHIZOCYTES
DREPANOCYTES
Anneaux de Cabot
DACRYOCYTES
ACANTOCYTES
Les Polyglobulies • Définition: augmentation Volume globulaire total • Orientation: augmentation GR, Hb, Ht • Confirmation: mesure Volume érythrocytaire total par dilution d’hématies marquées au Chrome 51 N: H 33 3 ml/kg, F 25 3 ml/kg • Fausses polyglobulies: hémoconcentration (augmentation GR, Hb, Ht, mais Vol. Glob. Total normal) par perte plasmatique, ou pseudo-polyglobulie de certaines thalassémies (augmentation GR mais GR microcytaire, donc Ht normal)
Les Polyglobulies • La maladie de Vaquez: Syndrôme myéloprolifératif Les Polyglobulies secondaires: les hypoxies chroniques d'origine respiratoires ou cardiaques, les causes congénitales par mutation du gène de l'hémoglobine et les causes tumorales par sécrétion inappropriée d'EPO.
La maladie de Vaquez syndrome myéloprolifératif classé dans les hémopathies malignes Examens hématologiques et biologiques: • Une polyglobulie importante, Hématocrite > 60% : masse globulaire > 50 ml/kg ; • • Une thrombocytose : plaquettes entre 400 et 1000 G/l ; • • Une hyperleucocytose rarement >20 G/l absence de myélémie sauf si myelofibrose associée • • Le myélogramme est inutile n’apportant que des arguments inconstants et indirects.
Les Polyglobulies secondaires = conséquence d’une augmentation de sécrétion d’érythropoïétine -suite à hypoxie tissulaire: -altitude -insuffisances respiratoires chroniques -maladies cardiaques -tabagisme chronique -suite à production anormale: -tumeurs rénales, cervelet, cancers ovariens, hépatiques